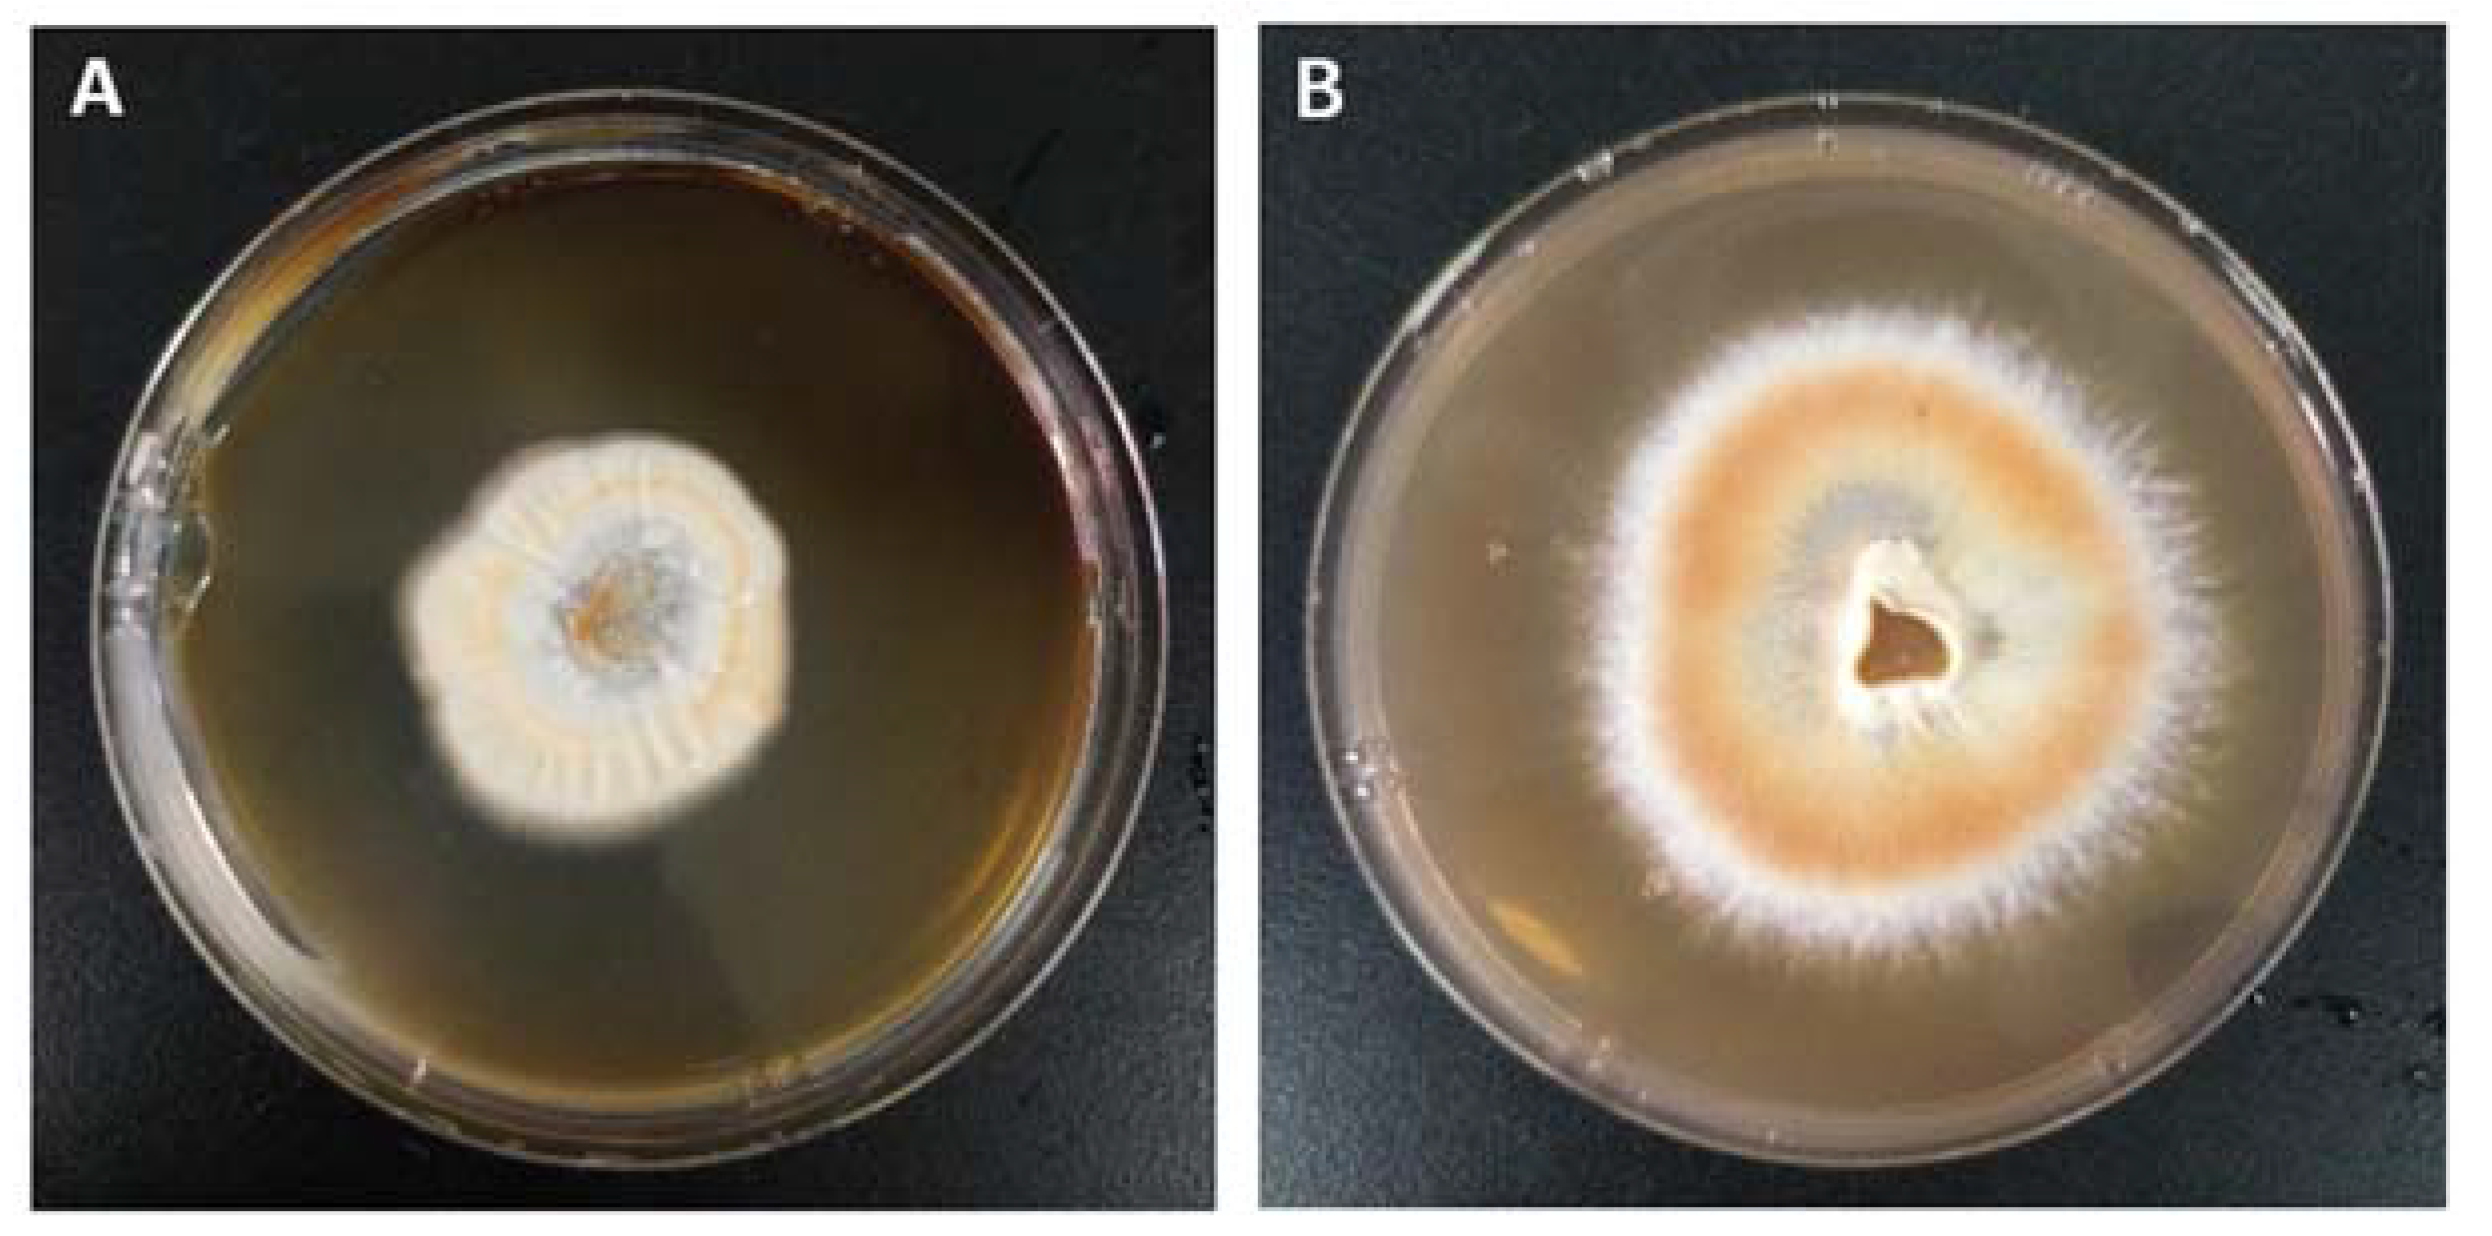
Molecules 28 03036 g003 Molecules 28 03036 g003

Selenium Enrichment of the Edible Medicinal Mushroom Antrodia camphorata by Submerged Fermentation
Abstract
1. Introduction
2. Results
2.1. Identification of Strain
2.2. Selection of Selenium-Enriched Fermentation Conditions
2.2.1. Effect of Temperature
2.2.2. Effect of Sodium Selenite Concentration
2.2.3. Effect of Liquid Filling Volume and Agitation
2.3. Contents of Inorganic and Organic Selenium in A. camphorata
2.4. In Vitro Antioxidant Activity of Polysaccharides
3. Discussion
4. Materials and Methods
4.1. Materials
4.2. Identification of A. camphorata
4.3. Selenium-Enriched Fermentation of A. camphorata
4.4. Total Se Determination in A. camphorata
4.5. Calculation of Selenium-Enriching Rate
4.6. Inorganic Selenium Determination in A. camphorata
4.7. Calculation of Organic Selenium Content in A. camphorata
4.8. Extraction of Polysaccharide and Determination of Selenium Polysaccharide Content in A. camphorata
4.9. Extraction of Total Soluble Protein and Determination of Selenoprotein Content in A. camphorata
4.10. In Vitro Antioxidant Activity of Polysaccharides
4.11. Statistical Analysis
5. Conclusions
Author Contributions
Funding
Data Availability Statement
Acknowledgments
Conflicts of Interest
Sample Availability
References
- Schroeder, H.A.; Frost, D.V.; Balassa, J.J. Essential trace metals in man: Selenium. J. Chronic Dis. 1970, 23, 227–243. [Google Scholar] [CrossRef] [PubMed]
- Fairweather-Tait, S.J.; Bao, Y.; Broadley, M.R.; Collings, R.; Ford, D.; Hesketh, J.E.; Hurst, R. Selenium in Human Health and Disease. Antioxid. Redox Signal. 2010, 14, 1337–1383. [Google Scholar] [CrossRef] [PubMed]
- Gać, P.; Czerwińska, K.; Macek, P.; Jaremków, A.; Mazur, G.; Pawlas, K.; Poręba, R. The importance of selenium and zinc deficiency in cardiovascular disorders. Environ. Toxicol. Pharmacol. 2021, 82, 103553. [Google Scholar] [CrossRef] [PubMed]
- Mehdi, Y.; Hornick, J.L.; Istasse, L.; Dufrasne, I. Selenium in the environment, metabolism and involvement in body functions. Molecules 2013, 18, 3292–3311. [Google Scholar] [CrossRef] [PubMed]
- Ullah, A.; Yin, X.; Wang, F.; Xu, B.; Mirani, Z.A.; Xu, B.; Chan, M.W.; Ali, A.; Usman, M.; Ali, N.; et al. Biosynthesis of Selenium Nanoparticles (via Bacillus subtilis BSN313), and Their Isolation, Characterization, and Bioactivities. Molecules 2021, 26, 5559. [Google Scholar] [CrossRef] [PubMed]
- Finger, J.W.; Hamilton, M.T.; Glenn, T.C.; Tuberville, T.D. Dietary Selenomethionine Administration in the American Alligator (Alligator mississippiensis): Hepatic and Renal Se Accumulation and Its Effects on Growth and Body Condition. Arch. Environ. Contam. Toxicol. 2017, 72, 439–448. [Google Scholar] [CrossRef]
- Sharma, S.; Kaur, N.; Kaur, S.; Nayyar, H. Selenium as a nutrient in biostimulation and biofortification of cereals. Indian J. Plant Physiol. 2017, 22, 1–15. [Google Scholar] [CrossRef]
- Jia, Y.; Guan, X.-Y.; Dai, C.-C. The Effects of Selenium on Polyunsaturated Fatty Acids of Diasporangium jonesianum. Appl. Biochem. Biotechnol. 2014, 172, 561–569. [Google Scholar] [CrossRef]
- Zhu, Y.-G.; Pilon-Smits, E.A.H.; Zhao, F.-J.; Williams, P.N.; Meharg, A.A. Selenium in higher plants: Understanding mechanisms for biofortification and phytoremediation. Trends Plant Sci. 2009, 14, 436–442. [Google Scholar] [CrossRef] [PubMed]
- Liu, J.; Wen, X.; Yajun, G.U. Optimization of Se-enriched fermentation conditions of Auricularia auricula. J. Hebei Univ. Nat. Sci. Ed. 2015, 35, 616. [Google Scholar] [CrossRef]
- da Silva, M.C.S.; Naozuka, J.; da Luz, J.M.R.; de Assunção, L.S.; Oliveira, P.V.; Vanetti, M.C.D.; Bazzolli, D.M.S.; Kasuya, M.C.M. Enrichment of Pleurotus ostreatus mushrooms with selenium in coffee husks. Food Chem. 2012, 131, 558–563. [Google Scholar] [CrossRef]
- Hu, T.; Hui, G.F.; Li, H.F.; Guo, Y.B. Selenium biofortification in Hericium erinaceus (Lion’s Mane mushroom) and its in vitro bioaccessibility. Food Chem. 2020, 331, 127287. [Google Scholar] [CrossRef]
- Chang, T.T.; Chou, W.N. Antrodia cinnamomea sp. nov. on Cinnamomum kanehirai in Taiwan. Mycol. Res. 1995, 99, 756–758. [Google Scholar] [CrossRef]
- Huang, C.-H.; Chang, Y.-Y.; Liu, C.-W.; Kang, W.-Y.; Lin, Y.-L.; Chang, H.-C.; Chen, Y.-C. Fruiting Body of Niuchangchih (Antrodia camphorata) Protects Livers against Chronic Alcohol Consumption Damage. J. Agric. Food Chem. 2010, 58, 3859–3866. [Google Scholar] [CrossRef] [PubMed]
- Huang, G.-J.; Huang, S.-S.; Lin, S.-S.; Shao, Y.-Y.; Chen, C.-C.; Hou, W.-C.; Kuo, Y.-H. Analgesic Effects and the Mechanisms of Anti-inflammation of Ergostatrien-3β-ol from Antrodia camphorata Submerged Whole Broth in Mice. J. Agric. Food Chem. 2010, 58, 7445–7452. [Google Scholar] [CrossRef] [PubMed]
- Geethangili, M.; Tzeng, Y.-M. Review of Pharmacological Effects of Antrodia camphorata and Its Bioactive Compounds. Evid. Based Complement. Alternat. Med. 2011, 2011, 212641. [Google Scholar] [CrossRef]
- Lee, I.H.; Huang, R.L.; Chen, C.T.; Chen, H.C.; Hsu, W.C.; Lu, M.K. Antrodia camphorata polysaccharides exhibit anti-hepatitis B virus effects. FEMS Microbiol. Lett. 2002, 209, 63–67. [Google Scholar] [CrossRef]
- Yu, Y.L.; Chen, I.H.; Shen, K.Y.; Huang, R.Y.; Wang, W.R.; Chou, C.J.; Chang, T.T.; Chu, C.L. A triterpenoid methyl antcinate K isolated from Antrodia cinnamomea promotes dendritic cell activation and Th2 differentiation. Eur. J. Immunol. 2009, 39, 2482–2491. [Google Scholar] [CrossRef]
- Ganesan, N.; Baskaran, R.; Velmurugan, B.K.; Thanh, N.C. Antrodia cinnamomea-An updated minireview of its bioactive components and biological activity. J. Food Biochem. 2019, 43, e12936. [Google Scholar] [CrossRef]
- Zhang, B.B.; Guan, Y.Y.; Hu, P.F.; Chen, L.; Xu, G.R.; Liu, L.; Cheung, P.C.K. Production of bioactive metabolites by submerged fermentation of the medicinal mushroom Antrodia cinnamomea: Recent advances and future development. Crit. Rev. Biotechnol. 2019, 39, 541–554. [Google Scholar] [CrossRef]
- Chen, Q.; Tang, H.; Zha, Z.; Yin, H.; Wang, Y.; Wang, Y.; Li, H.; Yue, L. β-d-glucan from Antrodia Camphorata ameliorates LPS-induced inflammation and ROS production in human hepatocytes. Int. J. Biol. Macromol. 2017, 104, 768–777. [Google Scholar] [CrossRef] [PubMed]
- Kuang, Y.; Li, B.; Wang, Z.; Qiao, X.; Ye, M. Terpenoids from the medicinal mushroom Antrodia camphorata: Chemistry and medicinal potential. Nat. Prod. Rep. 2021, 38, 83–102. [Google Scholar] [CrossRef] [PubMed]
- Lu, M.-Y.J.; Fan, W.-L.; Wang, W.-F.; Chen, T.; Tang, Y.-C.; Chu, F.-H.; Chang, T.-T.; Wang, S.-Y.; Li, M.-Y.; Chen, Y.-H.; et al. Genomic and transcriptomic analyses of the medicinal fungus Antrodia cinnamomea for its metabolite biosynthesis and sexual development. Proc. Natl. Acad. Sci. USA 2014, 111, E4743–E4752. [Google Scholar] [CrossRef] [PubMed]
- Lu, M.-C.; El-Shazly, M.; Wu, T.-Y.; Du, Y.-C.; Chang, T.-T.; Chen, C.-F.; Hsu, Y.-M.; Lai, K.-H.; Chiu, C.-P.; Chang, F.-R.; et al. Recent research and development of Antrodia cinnamomea. Pharmacol. Ther. 2013, 139, 124–156. [Google Scholar] [CrossRef] [PubMed]
- Fazenda, M.L.; Seviour, R.; McNeil, B.; Harvey, L.M. Submerged Culture Fermentation of “Higher Fungi”: The Macrofungi. In Advances in Applied Microbiology; Academic Press: Cambridge, MA, USA, 2008; Volume 63, pp. 33–103. [Google Scholar]
- Elisashvili, V.I. Submerged Cultivation of Medicinal Mushrooms: Bioprocesses and Products (Review). Int. J. Med. Mushrooms 2012, 14, 211–239. [Google Scholar] [CrossRef]
- Bakratsas, G.; Polydera, A.; Katapodis, P.; Stamatis, H. Recent trends in submerged cultivation of mushrooms and their application as a source of nutraceuticals and food additives. Future Foods 2021, 4, 100086. [Google Scholar] [CrossRef]
- Chen, S.Y.; Lee, Y.R.; Hsieh, M.C.; Omar, H.A.; Teng, Y.N.; Lin, C.Y.; Hung, J.H. Enhancing the Anticancer Activity of Antrodia cinnamomea in Hepatocellular Carcinoma Cells via Cocultivation With Ginger: The Impact on Cancer Cell Survival Pathways. Front. Pharmacol. 2018, 9, 780. [Google Scholar] [CrossRef]
- Yu, P.W.; Chang, Y.C.; Liou, R.F.; Lee, T.H.; Tzean, S.S. pks63787, a Polyketide Synthase Gene Responsible for the Biosynthesis of Benzenoids in the Medicinal Mushroom Antrodia cinnamomea. J. Nat. Prod. 2016, 79, 1485–1491. [Google Scholar] [CrossRef]
- Petre, M.; Petre, V. Chapter 1—Biotechnology of Mushroom Growth Through Submerged Cultivation. In Mushroom Biotechnology; Petre, M., Ed.; Academic Press: San Diego, CA, USA, 2016; pp. 1–18. [Google Scholar]
- Mariana, L.F.; Linda, M.H. Effects of dissolved oxygen on fungal morphology and process rheology during fed-batch processing of Ganoderma lucidum. J. Microbiol. Biotechnol. 2010, 20, 844–851. [Google Scholar]
- Hariharan, S.; Dharmaraj, S. Selenium and selenoproteins: It’s role in regulation of inflammation. Inflammopharmacology 2020, 28, 667–695. [Google Scholar] [CrossRef]
- Beilstein, M.A.; Whanger, P.D. Deposition of dietary organic and inorganic selenium in rat erythrocyte proteins. J. Nutr. 1986, 116, 1701–1710. [Google Scholar] [CrossRef] [PubMed]
- Ponce de León, C.A.; Bayón, M.M.; Paquin, C.; Caruso, J.A. Selenium incorporation into Saccharomyces cerevisiae cells: A study of different incorporation methods. J. Appl. Microbiol. 2002, 92, 602–610. [Google Scholar] [CrossRef] [PubMed]
- Rayman, M.P.; Infante, H.G.; Sargent, M. Food-chain selenium and human health: Spotlight on speciation. Br. J. Nutr. 2008, 100, 238–253. [Google Scholar] [CrossRef] [PubMed]
- Milovanović, I.; Brčeski, I.; Stajić, M.; Korać, A.; Vukojević, J.; Knežević, A. Potential of Pleurotus ostreatus Mycelium for Selenium Absorption. Sci. World J. 2014, 2014, 681834. [Google Scholar] [CrossRef] [PubMed]
- Song, F.; Su, D.; Keyhani, N.O.; Wang, C.; Shen, L.; Qiu, J. Influence of selenium on the mycelia of the shaggy bracket fungus, Inonotus hispidus. J. Sci. Food Agric. 2022, 102, 3762–3770. [Google Scholar] [CrossRef] [PubMed]
- Muszyńska, B.; Szacawa, E.; Bederska-Łojewska, D.; Dudek, K.; Pomierny, B.; Włodarczyk, A.; Kała, K.; Lazur, J.; Suchocki, P.; Budziszewska, B.; et al. Preliminary study on Se-enriched Lentinula edodes mycelium as a proposal of new feed additive in selenium deficiency. PLoS ONE 2020, 15, e0233456. [Google Scholar] [CrossRef]
- Xu, M.; Zhu, S.; Wang, L.; Wei, Z.; Zhao, L.; Shi, G.; Ding, Z. Influence of Selenium Biofortification on the Growth and Bioactive Metabolites of Ganoderma lucidum. Foods 2021, 10, 1860. [Google Scholar] [CrossRef]
- Kryukov, G.V.; Gladyshev, V.N. Mammalian selenoprotein gene signature: Identification and functional analysis of selenoprotein genes using bioinformatics methods. Methods Enzymol. 2002, 347, 84–100. [Google Scholar] [CrossRef]
- Clark, L.C.; Combs, G.F., Jr.; Turnbull, B.W.; Slate, E.H.; Chalker, D.K.; Chow, J.; Davis, L.S.; Glover, R.A.; Graham, G.F.; Gross, E.G.; et al. Effects of Selenium Supplementation for Cancer Prevention in Patients With Carcinoma of the Skin: A Randomized Controlled Trial. JAMA 1996, 276, 1957–1963. [Google Scholar] [CrossRef]
- Dumont, E.; Vanhaecke, F.; Cornelis, R. Selenium speciation from food source to metabolites: A critical review. Anal. Bioanal. Chem. 2006, 385, 1304–1323. [Google Scholar] [CrossRef]
- Xiang, A.; Li, W.; Zhao, Y.; Ju, H.; Xu, S.; Zhao, S.; Yue, T.; Yuan, Y. Purification, characterization and antioxidant activity of selenium-containing polysaccharides from pennycress (Thlaspi arvense L.). Carbohydr. Res. 2022, 512, 108498. [Google Scholar] [CrossRef] [PubMed]
- Zhao, Y.; Yan, B.; Wang, Z.; Li, M.; Zhao, W. Natural Polysaccharides with Immunomodulatory Activities. Mini Rev. Med. Chem. 2020, 20, 96–106. [Google Scholar] [CrossRef] [PubMed]
- Kozarski, M.; Klaus, A.; Jakovljevic, D.; Todorovic, N.; Vunduk, J.; Petrović, P.; Niksic, M.; Vrvic, M.M.; Van Griensven, L. Antioxidants of Edible Mushrooms. Molecules 2015, 20, 19489–19525. [Google Scholar] [CrossRef] [PubMed]
- Zhang, Y.; Wang, D.; Chen, Y.; Liu, T.; Zhang, S.; Fan, H.; Liu, H.; Li, Y. Healthy function and high valued utilization of edible fungi. Food Sci. Hum. Wellness 2021, 10, 408–420. [Google Scholar] [CrossRef]
- Wang, C.-L.; Huang, W.-C.; Chou, C.-J.; Lu, M.-K.; Huang, C.-J.; Tsai, J.; Tsai, P.-J. Aqueous extract of Antrodia cinnamomea reduced high-fat diet-induced obesity in mice and suppressed adipogenesis in 3T3-L1 cells. J. Funct. Foods 2017, 35, 185–196. [Google Scholar] [CrossRef]
- Liu, J.-J.; Huang, T.-S.; Hsu, M.-L.; Chen, C.-C.; Lin, W.-S.; Lu, F.-J.; Chang, W.-H. Antitumor effects of the partially purified polysaccharides from Antrodia camphorata and the mechanism of its action. Toxicol. Appl. Pharmacol. 2004, 201, 186–193. [Google Scholar] [CrossRef]
- Han, C.; Guo, L.; Yang, Y.; Li, W.; Sheng, Y.; Wang, J.; Guan, Q.; Zhang, X. Study on antrodia camphorata polysaccharide in alleviating the neuroethology of PD mice by decreasing the expression of NLRP3 inflammasome. Phytother. Res. 2019, 33, 2288–2297. [Google Scholar] [CrossRef]
- Maity, P.; Samanta, S.; Nandi, A.K.; Sen, I.K.; Paloi, S.; Acharya, K.; Islam, S.S. Structure elucidation and antioxidant properties of a soluble β-d-glucan from mushroom Entoloma lividoalbum. Int. J. Biol. Macromol. 2014, 63, 140–149. [Google Scholar] [CrossRef]
- Rajasekaran, M.; Kalaimagal, C. In vitro antioxidant activity of ethanolic extract of a medicinal mushroom, Ganoderma Lucidum. J. Pharm. Sci. Res. 2011, 3, 1427–1433. [Google Scholar]
- Shi, M.; Zhang, Z.; Yang, Y. Antioxidant and immunoregulatory activity of Ganoderma lucidum polysaccharide (GLP). Carbohydr. Polym. 2013, 95, 200–206. [Google Scholar] [CrossRef]
- Sun, Y.; Gan, Y.; Zhang, L.; Shi, Y.; Yue, T.; Yuan, Y. Isolation and identification of Monascus and evaluation of its selenium accumulation. LWT 2022, 154, 112887. [Google Scholar] [CrossRef]
- Nakaguchi, Y.; Hiraki, K.; Tamari, Y.; Fukunaga, Y.; Nishikawa, Y.; Shigematsu, T. Fluorometric Determination of Inorganic Selenium(IV), Selenium(VI) and Organic Selenium in Natural Waters. Anal. Sci. 1985, 1, 247–252. [Google Scholar] [CrossRef]
- Eva Moreno, M.A.; Pérez-Conde, C.; Cámara, C. Speciation of inorganic selenium in environmental matrices by flow injection analysis-hydride generation-atomic fluorescence spectrometry. Comparison of off-line, pseudo on-line and on-line extraction and reduction methods. J. Anal. At. Spectrom. 2000, 15, 681–686. [Google Scholar] [CrossRef]
- Song, H.; Zhang, Q.; Zhang, Z.; Wang, J. In vitro antioxidant activity of polysaccharides extracted from Bryopsis plumosa. Carbohydr. Polym. 2010, 80, 1057–1061. [Google Scholar] [CrossRef]
- Re, R.; Pellegrini, N.; Proteggente, A.; Pannala, A.; Yang, M.; Rice-Evans, C. Antioxidant activity applying an improved ABTS radical cation decolorization assay. Free Radic. Biol. Med. 1999, 26, 1231–1237. [Google Scholar] [CrossRef]
- Saleh, M.A.; Clark, S.; Woodard, B. Antioxidant and free radical scavenging activities of essential oils. Ethn. Dis. 2010, 20, 78–82. [Google Scholar]

| Temperature (°C) | Dry Weight (g/L) | Conc. of Se (µg/g) |
|---|---|---|
| 25 | 1.55 ± 0.06 a | 1156.9 ± 49.1 a |
| 30 | 1.45 ± 0.07 a | 872.0 ± 80.6 b |
| Conc. of Total Se (µg/g) | Conc. of Inorganic Se (µg/g) | Conc. of Organic Se (µg/g) | Percentage of Organic Se (%) |
|---|---|---|---|
| 1281.3 ± 105.1 | 152.8 ± 20.3 | 1128.5 ± 87.4 | 88.1 |
| Se-Polysaccharide | Selenoprotein | |
|---|---|---|
| Content of polysaccharide/protein (mg/g dry biomass) | 66.3 ± 3.9 | 58.2 ± 4.3 |
| Content of selenium (µg Se/g Se-polysaccharide or selenoprotein) | 694.7 ± 50.3 | 140.2 ± 9.3 |
| Percentage of organic selenium (%) | 61.5 | 12.4 |
| Percentage of total selenium (%) | 54.2 | 10.9 |
| Fraction | Yield (%) | Content of Selenium (µg/g) |
|---|---|---|
| ACP I | 13.14 | 45.82 ± 7.92 |
| ACP II | 45.57 | 176.44 ± 20.45 |
| ACP III | 6.43 | 70.87 + 6.98 |
| ACP IV | 19.29 | 202.35 ± 14.71 |
| Detection Parameters | Operating Conditions |
|---|---|
| Negative high voltage (V) | 250 |
| Lamp current (mA) | 80 |
| Carrier gas | Argon |
| Carrier gas flow (mL/min) | 300 |
| Shielding gas flow (mL/min) | 800 |
| Reading time (s) | 16 |
| Delay time (s) | 6 |
| Carry current | 0.6 mol/L hydrochloric acid |
| Reducing agent | Potassium borohydride concentration 2%, contain 0.5% NaOH |
Disclaimer/Publisher’s Note: The statements, opinions and data contained in all publications are solely those of the individual author(s) and contributor(s) and not of MDPI and/or the editor(s). MDPI and/or the editor(s) disclaim responsibility for any injury to people or property resulting from any ideas, methods, instructions or products referred to in the content. |
© 2023 by the authors. Licensee MDPI, Basel, Switzerland. This article is an open access article distributed under the terms and conditions of the Creative Commons Attribution (CC BY) license (https://creativecommons.org/licenses/by/4.0/).
Share and Cite
Li, J.; Wen, S.; Zhang, B.; Wang, F. Selenium Enrichment of the Edible Medicinal Mushroom Antrodia camphorata by Submerged Fermentation. Molecules 2023, 28, 3036. https://doi.org/10.3390/molecules28073036
Li J, Wen S, Zhang B, Wang F. Selenium Enrichment of the Edible Medicinal Mushroom Antrodia camphorata by Submerged Fermentation. Molecules. 2023; 28(7):3036. https://doi.org/10.3390/molecules28073036
Chicago/Turabian StyleLi, Jin, Sai Wen, Baoyuan Zhang, and Fenghuan Wang. 2023. "Selenium Enrichment of the Edible Medicinal Mushroom Antrodia camphorata by Submerged Fermentation" Molecules 28, no. 7: 3036. https://doi.org/10.3390/molecules28073036
APA StyleLi, J., Wen, S., Zhang, B., & Wang, F. (2023). Selenium Enrichment of the Edible Medicinal Mushroom Antrodia camphorata by Submerged Fermentation. Molecules, 28(7), 3036. https://doi.org/10.3390/molecules28073036

